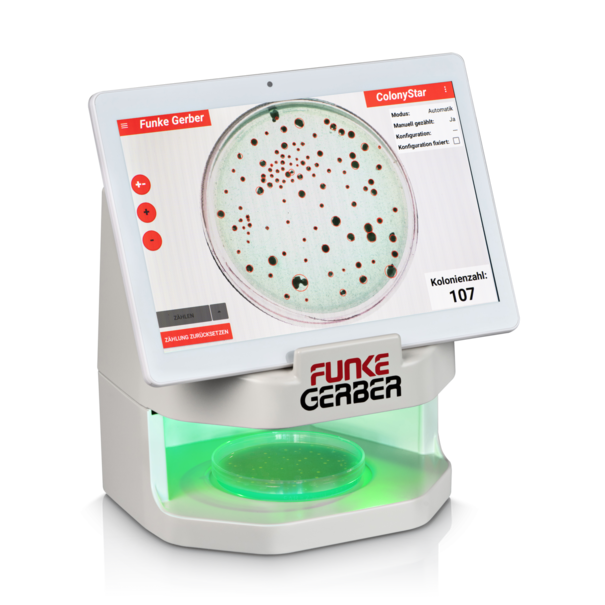
Счетчик колоний ColonyStar automatic со стандартным планшетом

Продукция Funke-Dr. N. Gerber Labortechnik GmbH
Страна производитель: Германия
5 Товаров




Счетчик колоний ColonyStar автоматический с улучшенным планшетом
8551
-
Производитель:
-
Гарантия:12 мес.
Готовится





